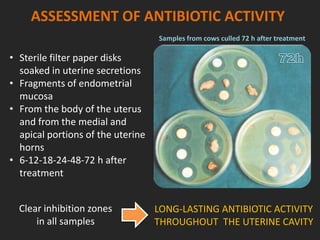
ASSESSMENT OF ANTIBIOTIC ACTIVITY
• Sterile filter paper disks
soaked in uterine secretions
• Fragments of endometrial
mucosa
• From the body of the uterus
and from the medial and
apical portions of the uterine
horns
• 6-12-18-24-48-72 h after
treatment
Clear inhibition zones
in all samples
Samples from cows culled 72 h after treatment
LONG-LASTING ANTIBIOTIC ACTIVITY
THROUGHOUT THE UTERINE CAVITY

Rifaximin is a semi-synthetic rifamycin antibiotic produced by Amycolatopsis mediterranei. It is non-absorbable and acts locally in the gut due to its unique chemical properties. Rifaximin has broad-spectrum activity against gram-positive and gram-negative bacteria as well as protozoa through inhibition of bacterial RNA polymerase. Its localized activity and lack of systemic absorption helps preserve other antibiotics and limits development of resistance. Rifaximin also has anti-inflammatory properties through activation of the pregnane X receptor, reducing levels of pro-inflammatory cytokines. Fatroximin dry cow is a rifaximin formulation developed for intramammary administration as dry cow therapy to





![RIFAXIMIN
Antimicrobial killing activity
• Rapidly kills fast-dividing bacteria as well as “persisters”
cells, which remain biologically inactive for long periods
evading antibiotic activity
– [Pozniak 1999]
• Bactericidal
• Actually kills
bacteria
Image](https://image.slidesharecdn.com/rifaximinbiopharmfinal-130809035837-phpapp02/85/Rifaximin-Fatro-worldwide-exclusive-antibiotic-6-320.jpg)




![DEVELOPMENT OF RESISTANCE TO RIFAXIMIN
• Studied in detail on several Gram- and
Gram+, aerobic and anaerobic strains
• Resistance to Rifaximin is rare
– [Hoover 1993; Ruiz 2008; Marchese 2000; Ouyang-Latimer 2011; Valentin 2011]
• More easily with sub-inhibitory concentrations
• Anaerobic atmosphere hinders the selection of
rifaximin-resistant bacteria
• High concentrations in in an oxygen-deficient milieu:
in-vivo occurrence of bacterial resistance with
rifaximin is an infrequent phenomenon](https://image.slidesharecdn.com/rifaximinbiopharmfinal-130809035837-phpapp02/85/Rifaximin-Fatro-worldwide-exclusive-antibiotic-11-320.jpg)

![SPREAD OF RESISTANCE TO RIFAXIMIN
• Resistance due to a chromosomal alteration
in the drug target, the DNA-RNA polymerase
(rpoB gene)
– [Al-Orainey 1990]
• Different from the plasmid-mediated
resistance common to other antibiotics
– [Smith 2002]
• The spread of resistance is less frequent than
that due to plasmid-mediated transfer
(transferred within the same generation, even
between different bacterial species)
– [Collignon PJ 2002]
Not disseminated by plasmids but mediated chromosomally
Sulfa
Β-lactamTetracycline
Fenicol
Aminoglicoside
multi-R
Plasmid](https://image.slidesharecdn.com/rifaximinbiopharmfinal-130809035837-phpapp02/85/Rifaximin-Fatro-worldwide-exclusive-antibiotic-13-320.jpg)




![RIFAXIMIN MODULATES THE
INFLAMMATORY RESPONSE
• Rifamycins are able to modulate neutrophil
functions and display anti-inflammatory actions
– [Spisani 1997]
• Intra-articular rifamycin has been successfully used
in chronic arthritis (juvenile rheumatoid arthritis and
ankylosing spondylitis)
– [Caruso 1997]
• Rifaximin reduces overall inflammatory status
modulating pro-inflammatory cytokine release
– IL-6, IL-1β, IL-8, IL-12 and interferon-γ, TNFα, chemokines
– [Brown 2010; Vitali 2009]](https://image.slidesharecdn.com/rifaximinbiopharmfinal-130809035837-phpapp02/85/Rifaximin-Fatro-worldwide-exclusive-antibiotic-18-320.jpg)
![RIFAXIMIN MODULATES INFLAMMATION
THROUGH PXR ACTIVATION
• Pregnane-X-Receptor mediates
the anti-inflammatory activities
of Rifaximin
– [Cheng 2010; Mencarelli 2011]
• PXR is a nuclear receptor (ligand-
activated transcription factor)
• NR are sensing systems that
govern the interactions between
genome and internal
environment
• PXR is activated by different
xenobiotics and endobiotics
RXR
GENE
TRANSCRIPTION
XRE
RFX
PXR
Expression of proteins
involved in detoxification
of foreign toxic substances](https://image.slidesharecdn.com/rifaximinbiopharmfinal-130809035837-phpapp02/85/Rifaximin-Fatro-worldwide-exclusive-antibiotic-19-320.jpg)



![INFLAMMATION ROLE IN CLINICAL MASTITIS
• The systemic and local inflammatory responses
contribute to etiology and pathophysiology of clinical
mastitis.
• The risk of developing clinical mastitis, from either
chronic infections or from new environmental
infections, is greatest during the peripartum period
– [Shpigel 1998]
• The inflammatory response is more aggressive during
the peripartum period than late lactation
– [Sordillo et al. 1995; , Lehtolainen et al. 2003]
• An enhanced inflammatory response with concomitant
suppression in other immune responses is involved in
the etiology and severity of the clinical mastitis
observed in peripartum cows
– [Ballou 2012]](https://image.slidesharecdn.com/rifaximinbiopharmfinal-130809035837-phpapp02/85/Rifaximin-Fatro-worldwide-exclusive-antibiotic-23-320.jpg)
![INFLAMMATION & METABOLIC DISORDERS
• During infections the local release of pro-inflammatory
cytokines also trigger an acute phase reaction
• Systemic inflammation increases lipolysis and impairs
hepatic metabolism, predisposing cows to lipid-related
metabolic diseases [Jiang 2008]
– reduced feed intake, energy diversion toward febrile
response, increased catabolism in adipose tissue and skeletal
muscle, acute phase protein synthesis in hepatic tissue and
impaired liver function
INCREASED RISK OF DEVELOPING KETOSIS AND FATTY LIVER](https://image.slidesharecdn.com/rifaximinbiopharmfinal-130809035837-phpapp02/85/Rifaximin-Fatro-worldwide-exclusive-antibiotic-24-320.jpg)
![PXR ACTIVATION BY RIFAXIMIN MAINTAINS
EPITHELIAL BARRIER INTEGRITY
• Epithelial cells are the first
line of defense against
harmful agents (bacteria
products and toxins) and act
as a “barrier” against bacteria
• Remarkably similar to
hepatocytes in their ability to
carry out detoxification
• Epithelial cells may become
unable to detoxify toxic
metabolites in inflammation
[Mencarelli 2010]
RXR
TRANSCRIPTION
OF GENES
INVOLVED IN
EPITHELIAL
DETOXIFICATION
AND PROTECTION
XRE
RFX
PXR](https://image.slidesharecdn.com/rifaximinbiopharmfinal-130809035837-phpapp02/85/Rifaximin-Fatro-worldwide-exclusive-antibiotic-25-320.jpg)